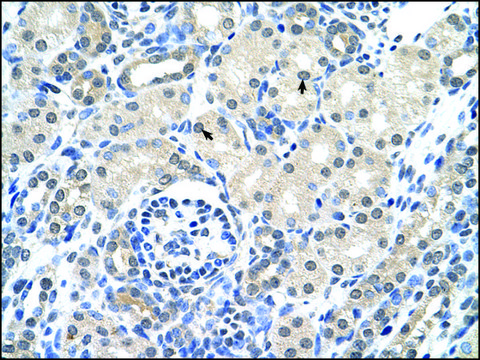

Anti-KRT17 antibody produced in rabbit
Synonym(s):
Anti-PCHC1, Anti-39.1 antibody produced in rabbit, Anti-CK-17 antibody produced in rabbit, Anti-Cytokeratin-17 antibody produced in rabbit, Anti-JUP antibody produced in rabbit, Anti-K17 antibody produced in rabbit, Anti-Keratin, type I cytoskeletal 17 antibody produced in rabbit, Anti-Keratin-17 antibody produced in rabbit, Anti-K17, Anti-Keratin 17, Anti-PC, Anti-PC2
Products
Product Category
Brand
Biological Source
Clonality
Feature
Gene Alias
Physical Form
Product Line
Antibody Form
Research Area
Conjugate
Quality Segment
Post Translational Modification
Species Reactivity
Technique
Showing 1-4 of 4
Compare
Product Number
Description
Pricing